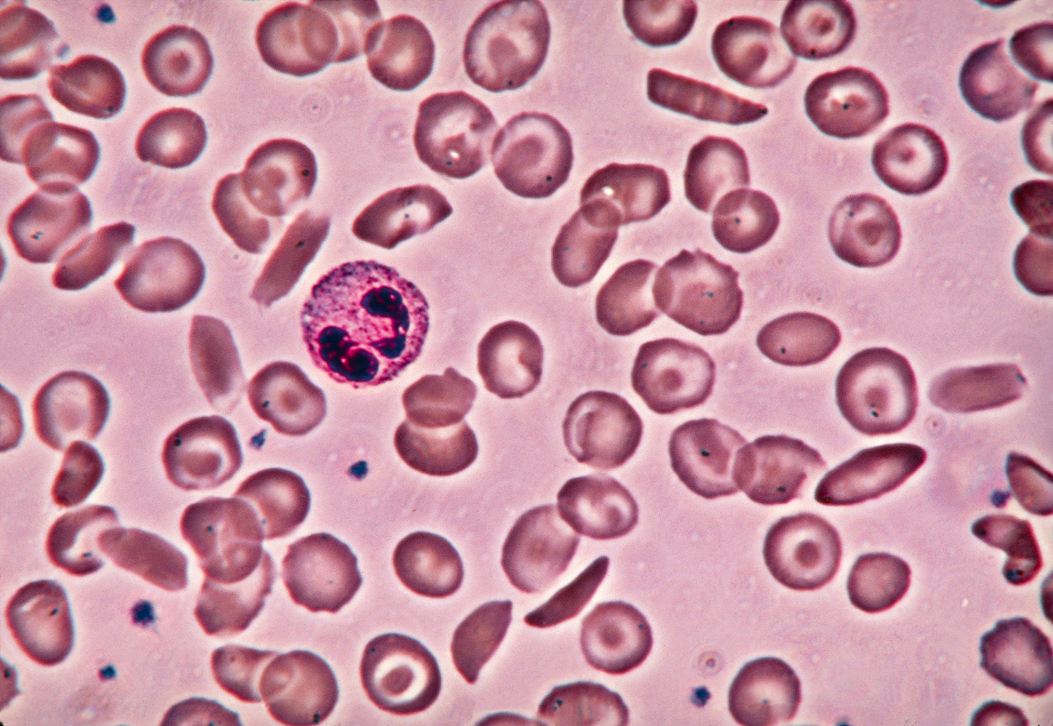

A Potential New Way to Treat Sickle Cell Disease
Designed for You
We are
We are scientists, researchers, doctors and drug developers. We are people who devote each day to finding new ways to treat diseases, including sickle cell disease (SCD).
Sickle Cell Disease
Understanding sickle cell disease
Sickle cell disease affects millions of people globally. When red blood cells become crescent-shaped, or “sickled”, they clog small blood vessels, break apart, and reduce oxygen delivery, leading to painful crises and tissue damage. Over time, damage can become permanent.
Our focus on fetal hemoglobin
Hemoglobin is a protein in red blood cells that carries oxygen. Babies have fetal hemoglobin, but by age one, red blood cells switch to making adult hemoglobin. In sickle cell disease, a gene mutation creates abnormal hemoglobin, causing the sickle shape. Increasing fetal hemoglobin can help, but current drugs can’t do this safely without side effects.
At Cellarity, we have discovered a new way to produce fetal hemoglobin in red blood cells instead of making sickle hemoglobin.
How It Works
Globin switching
CLY-124 is an investigational medicine that we designed specifically to treat sickle cell disease. It is a once-daily oral pill that we are testing now in a clinical trial.
Think of it like a train on tracks. Our investigational drug, CLY-124, acts like a switch, guiding the train onto the track that makes fetal hemoglobin. This process is called globin switching. Inside new red blood cells, when it’s time to make hemoglobin, the cells choose between fetal or adult types. CLY-124 helps them pick fetal hemoglobin instead.
Why Fetal Hemoglobin?
Boosting fetal hemoglobin
CLY-124 promotes globin switching to boost fetal hemoglobin and reduce sickle hemoglobin in SCD patients. Animal tests showed CLY-124 increases fetal hemoglobin without lowering cell counts or causing DNA damage. These findings informed our new clinical trial, which will study CLY-124’s safety, optimal dose, and ability to raise fetal hemoglobin in people with sickle cell disease.
For every 1% increase in fetal hemoglobin, there is a 4-6% decrease in pain crises*
* Blood; 144(Supplement 1): 1124. Nov 2024.
About the Trial

The CLY-124 clinical trial
The trial will enroll adults 18–55 years old who have been diagnosed with SCD and who have not received gene therapy or a stem cell transplant. Additional criteria will apply.
Participants will take CLY-124 by mouth, either a single dose or daily for 28 days. The trial team will closely monitor participants with check-ins and lab tests during and after treatment.
All trial care and medicine are provided at no cost. Travel support and compensation are also provided.
Clinical trials are an essential part of testing a potential new medicine before it can be approved by regulators for patient care. Many measures are in place to protect the safety of the participants and individuals can choose to withdraw at any time.
Commitment fuels our work
At Cellarity, we have developed a way to see the complex interactions between genes and cells that cause disease. We then design medicines to switch cell states from diseased to healthy – what we call “Cell State-Correcting” medicines.
Our work in sickle cell disease is driven by the goal of helping as many patients as possible.
Questions? We’re here for you.
If you’d like to learn more about investigational medicines and clinical trials, start by talking to your doctor.
For more information about CLY-124, contact us and a member of our clinical team will get back to you.